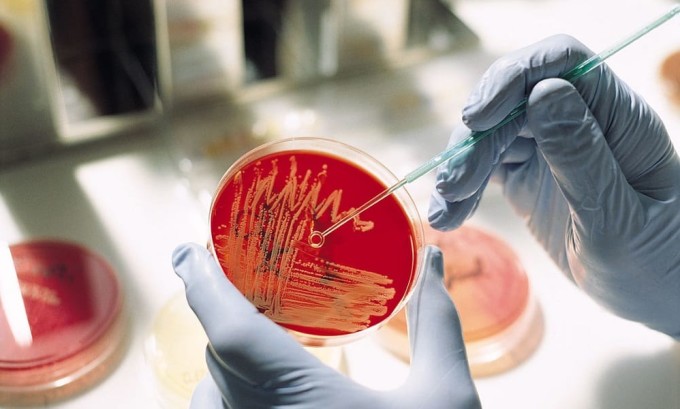

Цистит не проходить і не виліковується: довго (тиждень, місяць), чому і що робити
Чому загострюється цистит?
Хронічний цистит проявляється і як самостійна хвороба, так і внаслідок невиявлених хвороб органів сечостатевої системи. Недуга може загостритися в результаті попадання в організм кишкової палички, заселення слизових патогенними бактеріями стафілокока, стрептокока та інших.
Проявляється захворювання при передчасному перериванні терапії антибіотиками. Часто, після того, як перші ознаки хвороби проходять, людина припиняє прийом препаратів, а це неправильно. Тривалість лікування повинна бути не менше 7-10 днів, а при циститі і більше.
https://www.youtube.com/watch?v=NCjmNsrqrlI
У більшості випадків, а саме у 80-ти відсотках, запалення сечового міхура виникає в результаті активного розмноження кишкової палички. Це безпосередньо пов’язано з недотриманням правил особистої гігієни.
- Гриби Кандида;
- Інфекція;
- Поява каменів;
- Ракові захворювання;
- Патогенні бактерії.
Тим не менш, тут також впливає психоемоційним фактор. Хвороба з’являється у представниць прекрасної статі в шість разів частіше, чим у чоловіків. Це пов’язано з досить широким сечівником, куди легко проникають шкідливі мікроорганізми.
Чоловіки схильні до появи запалення сечового міхура в більш зрілому віці. Зазвичай воно виникає на тлі присутніх захворювань, таких як хронічний простатит або аденома простати.
Розвитку хронічного запалення в сечовому міхурі сприяє кілька факторів, серед яких:
- несвоєчасне і неграмотне лікування гострого циститу;
- ігнорування симптомів вперше виниклого патологічного процесу;
- наявність в організмі вогнищ хронічної інфекції;
- імунодефіцитні стани;
- вагітність, менопауза у жінок.
Головною причиною появи неприємних симптомів у чоловіків та жінок репродуктивного віку є активне статеве життя і часта зміна партнерів. Хронічний цистит у більшості клінічних випадків діагностується у людей, які не дотримують правил особистої гігієни і зневажають рекомендаціями лікарів. Патологічний процес загострюється після:
- загального переохолодження організму;
- перенесених вірусних інфекцій, які супроводжуються виснаженням імунних сил;
- стресових ситуацій;
- тривалих закрепів;
- вживання в їжу великої кількості жирної, солоної і гострої їжі;
- хронічного безсоння;
- запущених форм урогенітальних інфекцій;
- малого вживання рідини (менше 1,5-2 літра води на добу).
Загострення хронічного циститу – постійний супутник людей, які схильні стримувати сечовипускання. Спровокувати рецидив хвороби може сидяча робота, коли людина по 5-7 годин на добу знаходиться в сидячому положенні.
Як проводиться лікування
Якщо процес запалення в сечовому міхурі трансформувався в хронічну форму перебігу і загострився, його необхідно негайно лікувати. Ні в якому разі не можна ігнорувати симптоми хвороби, так як з часом вони будуть тільки прогресувати.
Всі маніпуляції, пов’язані з терапією недуги, повинні виконуватися виключно лікарем. Самолікування при даному розвитку подій суворо заборонено через ризик виникнення тяжких наслідків.
При загостренні циститу лікування повинно бути комплексним. Терапія захворювання переслідує кілька цілей:
- усунення вогнища хронічної інфекції;
- ліквідація проявів запалення;
- нормалізація сечовидільної функції;
- відновлення слизової оболонки;
- попередження повторних загострень.
Отже, що робити, якщо виникло чергове загострення? При появі перших симптомів запального процесу людині слід негайно звернутися за кваліфікованою медичною допомогою. Лікування даного захворювання та його рецидивів займається лікар-уролог, який в ході об’єктивного обстеження та аналізу результатів обстеження пацієнта визначиться з клінічною формою і причинами розвитку недуги.
Лікування загострень включає в себе:
- призначення пацієнту спеціальної дієти з виключенням з харчового раціону гострої, солоної і жирної їжі, а також алкоголю, солодощів і спецій;
- нормалізацію питного режиму;
- антибактеріальну та протимікробну терапію, яка реалізується шляхом призначення препаратів, активних по відношенню до інфекції;
- знеболюючі засоби переважно з групи спазмолітиків;
- нестероїдні протизапальні препарати, що дозволяють ліквідувати прояви запального процесу;
- фізіотерапевтичні процедури, зокрема, УВЧ, фонофорез тощо.
Хірургічна корекція недуги показана пацієнтам, у яких часті загострення спровоковані дефектами розвитку сечовивідних шляхів, що сприяє розвитку в них інфекції і блокує процес нормального відтоку сечі.
Доведено, що деякі трави здатні надавати досить сильний антисептичну, сечогінну та протизапальну дію по відношенню до тканин людського організму. Тому класичні терапевти не заперечують ефективності народних методів лікування загострень циститу, хоча попереджають про необхідність їх застосування виключно у вигляді додаткової терапії.
В першу чергу, як тільки пацієнт прийшов на прийом, йому призначаються всі аналізи, а вже потім складається грамотне лікування лікарем, куди входить певна група лікарських засобів. На жаль, ці медикаменти не можуть назавжди позбавити від циститу, тому він легко може виникнути знову.
Зазвичай лікар призначає в залежності від збудника захворювання протигрибкові або противірусні лікарські засоби, універсальні антибіотики і медичні препарати, які відновлюють мікрофлору.
Тим не менш, лікар призначить пацієнту комбінований курс лікування, куди входять наступні цикли:
- Етіологічний. При ньому проводиться знищення збудника захворювання.
- Патогенетичний. Він спрямований на знищення патогенних мікроорганізмів в тканини сечового міхура.
- Профілактичний.
Щоб був реалізований перший цикл терапії, що застосовуються антибактеріальні препарати, які борються з певним видом збудника захворювання. З присутніх в аптеках лікарських засобів, перевага віддається медикаментам, які якісно борються із запальними процесами і не справляють негативного впливу на організм пацієнта, а саме: Пефлоксацину, гатифлоксацину мікро, Ципрофлоксацину, Левофлоксацину та іншим.
Звичайний курс терапії циститу складає десять днів. З уросептиків використовуються медикаменти, які входять нитрофурановую групу, а саме: Фурадонін, Фуразолідон або Фурагін.
При перших нападах загострення хронічного циститу потрібно негайно звернутися до лікаря. Тільки кваліфікований фахівець зможе призначити ефективний терапевтичний курс. Хронічну фазу перебігу циститу виявити набагато складніше через смазанности клінічної картини та особливостей симптоматики.
Для визначення майбутньої тактики лікування пацієнти повинні будуть пройти ряд лабораторних та бактеріологічних аналізів, що дозволяють виявити конкретний вид вірусного або бактеріального мікроорганізму, який спровокував запалення сечостатевої системи.
Лікування циститу, який загострився, багато в чому схожий на тактику медикаментозного впливу при гострому перебігу недуги.
У першу чергу хворі повинні дотримувати постільний режим, тепло одягатися та не допускати переохолодження організму. Лікуючий лікар обов’язково порекомендує хворого з запаленням сечового міхура дотримуватися щадний режим харчування.
Базовим симптомом при інфекційно-запальних захворюваннях сечостатевої системи є відчуття печіння і поколювання в уретрі при природному відтоку сечі. З цієї причини велика частина пацієнтів намагаються рідше ходити в туалет при позивах до сечовипускання.
Однак такі дії є абсолютно неправильними. При нападах загострення запалення слід якомога більше пити рідини для швидкого виведення токсинів з сечового міхура. Для цієї мети підходить і звичайна дистильована вода, і журавлинний морс, трав’яні відвари.
Що стосується медикаментозного впливу, то лікарі роблять акцент на призначення таких препаратів:
- антибіотики з фармакологічної групи цефалоспоринів, фторхінолонів;
- нітрофуранові (антимікробні) медикаменти: Фуразидин, Фурагін;
- сульфаніламідні (препарати з яскраво вираженим бактеріостатичним ефектом впливу): Сульфаметизол;
- для швидкого купірування хворобливої симптоматики рекомендується приймати спазмолітики, ефективно розслаблюючі стислі м’язи сечового міхура: Папаверин, Диклофенак.
Хворим, які страждають від частих рецидивних спалахів хронічного циститу, слід пам’ятати про необхідність регулярного проведення профілактичних заходів, які полягають у загартовуванні організму, дотримання питного режиму, прийом вітамінних комплексів, помірних заняттях спортом.
Якщо цистит різко загострився, потрібно негайно розпочати медикаментозну терапію. Лікування підбирає лікар-уролог, який грунтується на результатах лабораторних аналізів та інструментальних дослідженнях.
Заходи профілактики
Що роблять жінки, якщо загострюються симптоми циститу, адже це приносить чимало дискомфорту? Взагалі кожна жінка повинна проводити профілактику захворювання. Для цього просто слід стежити за своїм здоров’ям і постійно зміцнювати імунну систему, пити вітамінні комплекси, суворо дотримувати всі призначення і рекомендації лікаря.
Профілактикою може бути загартування, яке зміцнює імунітет, піші прогулянки на свіжому повітрі, активна життя, заняття фізкультурою. Такі нескладні правила допоможуть знизити ризик появи захворювання.
Постійна поява запалення сечового міхура негативно позначається на емоційному стані хворого. При терапії хвороби необхідно дотримуватися заходів профілактики. До них відносяться:
- Дотримуватись загальних правил особистої гігієни. Це стосується підмивання при місячних, а також частій зміні прокладок, правильного витирання після спорожнення кишечника і підмиванні після статевого акту.
- Ходити «по-маленькому» не менше п’яти разів за день. Щоб не з’явилося подразнення сечового міхура, жінці варто обов’язково сходити в туалет після інтимної близькості.
- Стежити, щоб не було переохолодження.
- Скоротити вживання спиртних напоїв до мінімуму або повністю від них відмовитися.
- Носити тільки зручне і комфортне нижня білизна.
- Правильне харчування.
Не секрет, що хронічний цистит і його загострення завжди легше попередити, чим потім вилікувати. Профілактика захворювання полягає в наступному:
- дотримання правил особистої гігієни;
- контроль питного режиму і раціоналізація харчування;
- зміцнення стан імунної системи, регулярні прогулянки на свіжому повітрі, активний спосіб життя;
- попередження переохолодження, носіння одягу по сезону, відмова від незручного і сдавливающего нижньої білизни;
- поліпшення умов праці з організацією, у разі необхідності, розминок при тривалому знаходженні в сидячому положенні;
- санація хронічних вогнищ інфекції;
- профілактичні огляди і спостереження у фахівця;
- своєчасне лікування гострого циститу.
Головне завдання профілактики загострень – попередити рецидиви і усунути всі провокують їх появу фактори. Тому лікарі не втомлюються повторювати, що при перших симптомах недуги, навіть мінімальних, не варто займатися народним лікуванням і, тим більше, сподіватися на диво самовидужання, а негайно звертатися до фахівців за кваліфікованою допомогою.
Що робити, якщо хвороба часто рецидивує і приносить багато дискомфорту? Показано проводити профілактичні процедури. Людині потрібно стежити за здоров’ям та імунітетом, приймати вітаміни, дотримувати рекомендації лікаря.
Загартування теж сприяє зміцненню імунітету, а прогулянки на свіжому повітрі, активний спосіб життя і лікувальна фізкультура допоможуть поліпшити самопочуття, хвороба більше не загостриться. Дієтотерапія теж приносить хороший ефект при хронічному недугу, і якщо цистит часто рецидивує, то за харчуванням потрібно стежити постійно.
Правильні лікарські препарати
Правильний спосіб терапії підбирається тільки лікарем в індивідуальному порядку.
Також чудово допомагають свічки, вони здатні зняти запальний процес і впоратися з різними мікробами. Також хронічний недуга лікують і фізіотерапевтичними методами, вони паралельно з ліками, швидко нададуть позитивний результат. Для цього використовують прогрівання, магнітотерапію, іонофорез, лазерне лікування.
Ознаки захворювання під час загострення
Характерними ознаками захворювання, які виявляються частіше за все називають:
- Часті позиви до сечовипускання, з малою кількістю урини.
- Больові відчуття при спорожненні сечового міхура.
- Темний колір сечі.
- Гострий біль в області попереку.
- Збільшення температури до тридцяти дев’яти градусів.
- Нудота, напади блювоти слабкість в організмі і запаморочення.
Причини загострення захворювання
Для того щоб вчасно звернутися за допомогою до фахівця і почати адекватне лікування, необхідно знати основні симптоми циститу, а саме:
- Хворий відчуває сильну або помірний біль в надлобковій області.
- Виникають часті позиви до сечовипускання, при цьому сам процес супроводжується різзю, свербінням і болем, особливо в кінці спорожнення сечового.
- Сама порція що виділяється за один раз сечі дуже мала.
- Сеча відрізняється мутність, нерідко в ній присутня кров.
Провокувати цистит може запалення статевих органів, які знаходяться поруч з сечовим міхуром і уретрою. Іноді причиною захворювання є занадто бурхливе статеве життя.
У нашій країні лікар-урогінекології поки ще рідкість, тому цією проблемою займаються, як правило, гінекологи. При перших ознаках захворювання можна звернутися і до уролога, головне – не запустити хворобу, тому що в цьому випадку вже доведеться лікувати більш серйозні наслідки.
Мова йде про пієлонефрит – захворювання нирок. Ця хвороба лікується тільки в стаціонарі, під постійним наглядом лікаря. Якщо пустити на самоплив і цю хворобу, ви ризикуєте отримати інвалідність, так як при цій хворобі пригнічується функція нирок.
Іншим можливим ускладненням циститу є інтерстиціальний цистит, при якому хворий відвідує туалет 90-100 разів за добу. Це обумовлене патологічними змінами стінок сечового міхура, і повернути їм колишні функції буває вже дуже непросто.
При загостренні циститу необхідно знати, що робити при черговому нападі захворювання. У цьому допоможе тільки лікар, який складе індивідуальний план лікування, спираючись на результати лабораторних та бактеріологічних аналізів, інструментальних досліджень.
Лікарі не даремно підкреслюють важливість повного проходження терапевтичного курсу при діагностуванні циститу. Хвороблива симптоматика зменшується після кількох днів прийому призначених антибактеріальних, протимікробних препаратів.
В результаті цього пацієнти будуть з певною періодичністю страждати від повторюваних нападів загострення недуги.
Щоб уникнути таких ситуацій, значною мірою погіршують якість життя, пацієнти повинні пам’ятати про фактори, що провокують ускладнення запалення сечового міхура.
Сприяючий чинник | Специфічні особливості |
---|---|
Переважання в харчовому раціоні гострих, смажених, солоних страв | Така їжа провокує зайву дратівливість слизових оболонок не тільки шлунково-кишкового тракту, але і сечовидільної системи. У результаті загострюється хронічне запалення сечового міхура |
Переохолодження тазових органів | Навіть при незначній застуді, перестуживании тазу у людини в значній мірі знижуються захисні функції імунітету. Саме на тлі зменшення стійкості організму до дії патогенної мікрофлори спостерігаються напади циститу хронічної фази протікання |
Надмірне зловживання кофеїном, алкогольними напоями | Складові компоненти цих напоїв також чинять негативний вплив на чутливі слизові оболонки полого органу видільної системи, активуючи наявне запалення |
Тривалий відтягування моменту сечовипускання при виникненні природних позивів | Лікарі попереджають, що ситуації, коли пацієнти довго терплять і не спорожняти вчасно сечовий міхур, суттєво підвищують ризик розвитку інтоксикації всього організму. Крім цього в стінках органу створюються сприятливі умови для активного росту і поділу хвороботворних мікроорганізмів |
Якість нижньої білизни | Як показує медична практика, у жінок найбільш часто діагностується загострення циститу, якщо вони носять занадто тісна нижня білизна з синтетичних тканин |
Препарати для контрацепції, базовим компонентом яких виступають сперміциди | Речовини, що руйнують сперматозоїди надають токсичну дію на сечостатеву систему. З цієї причини багато контрацептиви по праву сприймаються як збудники хронічного циститу |
Гінекологічні захворювання | При відсутності адекватної терапії молочниці, вагінального кандидозу у жінок спостерігаються часті рецидивні спалаху запалення полого органу видільної системи |
Основними факторами, що впливають на прояв циститу можна назвати:
- Часте перебування людини на холоді.
- Сидячий спосіб життя.
- Постійні проблеми з запорами.
- Шкідливі звички, незбалансоване харчування.
- Недостатня кількість споживаної рідини.
- Не вчасно розпочате лікування хвороби.
- Хронічні патології сечової системи.
- Безсоння, стресові ситуації, порушення режиму робота/відпочинок.
- Самолікування.
Захворювання в основному з’являється з-за поганої особистої гігієни. Також під «приціл» недуги потрапляють люди, які часто змінюють сексуальних партнерів. Щоб після лікування, захворювання не виникло знову, необхідно правильно стежити за гігієною, своєчасно проводити профілактику. А якщо з’явилися перші ознаки недуги, слід негайно звернутися за допомогою до лікаря.
Хронічний цистит може бути первинним захворюванням, а не з’явитися з-за якогось хронічного захворювання. Не обов’язково, що ця недуга буде причиною патології сечової системи людини. Загострення циститу можливо, якщо в організм потрапить кишкова паличка, бактерія стафілокок, стрептокок або інші інфекції.
Якщо вчасно почати лікування, то можливо позбутися від цих «недругів», за короткий час. Тільки будь-яке медикаментозне лікування необхідно проводити під наглядом лікаря. Також не варто забувати, що в лікуванні допоможе і народна медицина, вона не тільки зміцнити здоров’я людини, але і імунітет.
Якщо ви перериваєте лікування антибіотиками, то відбувається загострення циститу і що ж робити в цьому випадку, людина не знає, доки не проконсультується з лікарем. Таке може статися, коли при перших відступи симптомів, хворий припиняє приймати медикаментозні засоби, чого робити зовсім не можна.
Пам’ятайте, що постійне переохолодження організму, слабкий імунітет, жіночі захворювання, також можуть спровокувати поява циститу.
Головні фактори, що провокують загострення хронічного циститу, є:
- регулярне переохолодження організму;
- малорухливий спосіб життя;
- проблеми з дефекацією і хронічні запори;
- погане харчування, зловживання шкідливими звичками;
- недотримання питного режиму;
- несвоєчасне лікування хвороби;
- хронічні хвороби органів сечостатевої системи;
- нервова перевтома, порушення режиму сну і відпочинку;
- самолікування.
Першопричиною хвороби є і недотримання правил особистої гігієни. Часто страждають недугою жінки і чоловіки, які постійно змінюють статевих партнерів. Щоб уникнути рецидиву хвороби, потрібно стежити за своїм здоров’ям і гігієною, вчасно приймати профілактичні заходи і при прояві першого симптому звернутися за медичною допомогою.
Провокуючі фактори
Доведено, що запалення сечового міхура пов’язане з гормональним фоном. При менопаузі ризик розвитку цієї хвороби зростає. Крім того, у жінок з віком опускаються органи малого тазу, що в кілька разів підвищує ризик заразитися інфекцією.
Багато хто скаржиться на те, що захворювання не проходить навіть після курсу прийому антибіотиків. Але в цьому випадку важливо знати збудника захворювання, щоб вибрати антибіотик, здатний вбити саме цей штам бактерій.
Підвищеного ризику піддаються діабетики, а також ті, у кого виявлена кишкова паличка, стрептококи, стафілококи і т. п. Мікроби можуть потрапити в сечовий міхур з будь-якого органу, в якому є хронічне запалення.
Хворий може дивуватися, чому у нього не проходить цистит, хоча причиною може бути звичайний карієс або хронічний тонзиліт. Іноді провокатором захворювання виступають лікарські препарати, що подразнюють слизову сечового міхура.
Вилікувати гострий цистит нескладно, головне – приймати антибіотики суворо за призначенням лікаря. Але і тут є особливості: лікарі наполягають на тому, щоб весь період, поки пацієнта мучить сильний біль, він знаходився в ліжку.

При менопаузі ризик розвитку циститу зростає.
Жінкам обов’язково потрібно зробити бакпосів. Це лабораторне дослідження передбачає зішкріб виділень з уретри, піхви і цервікального каналу і приміщення його в сприятливе середовище для розвитку мікробів. Цей аналіз дозволяє визначити збудника хвороби і призначити адекватне лікування.

Не можна безконтрольно приймати антибіотики і пити у великих дозах уросептики. Необхідно пам’ятати, що за допомогою одного ліки не можна знищити всі патогенні мікроби.
Не до кінця вилікуваний гострий цистит може спровокувати рецидив. Тому при перших ознаках поліпшення хворий перестає приймати таблетки, хоча мінімальний курс лікування розрахований на 7 днів. В результаті захворювання переходить в хронічну форму.
Ще дуже важливо дотримуватися дієти під час лікування не їсти гостру і солону їжу, приправи, консерви та інші продукти, здатні дратувати стінки сечового міхура. Газовану мінеральну воду пити не варто.
Отже, цистит провокують:
- Гінекологічні захворювання та ІПСШ. У чоловіків це також простатит і везикуліт.
- Неправильне або закінчена раніше строку лікування.
- Повторне зараження інфекцією іншого штаму.
- Велике навантаження на поперек або якась травма.
Розлад сечового міхура може бути наслідком ендокринних, нейровегетативних та психовегетативних збоїв. Виникнення циститу може бути пов’язано з абортом і патологією роботи яєчників.
Цей стан виникає через гормонального дисбалансу – нестачі гормону естрогену, що може вплинути на роботу сечового міхура.

Дуже важливо дотримуватися дієти під час лікування не їсти гостру і солону їжу, приправи, консерви та інші продукти, здатні дратувати стінки сечового міхура.
Різновиди циститу в період рецидиву
Причиною появи гострої форми, можна назвати переохолодження організму або виникнення інфекційного захворювання. При появі перших ознак, необхідно терміново розпочати лікування, якщо цього не зробити, захворювання переходить в хронічну форму. Лікувати її набагато складніше.
До того ж всі прояви не такі яскраві, і хворий просто може не помічати симптомів. З-за цього вони не звертаються за допомогою, а це перший крок до прояву рецидивів. Загострення хронічного циститу може статися із-за прихованого захворювання внутрішніх органів, тому необхідно проходити щорічне профілактичне обстеження, щоб вчасно виявити такі патології.
Лікарі розділяють запалення на гостру і хронічну форму. При гострому перебігу запалення вражає слизові тканини мочевіка, а першопричиною є переохолодження та інфекційне ураження. Якщо не почати своєчасне і адекватне лікування, хвороба приймає хронічну форму, з якою боротися набагато важче.
При хронічному перебігу ознаки хвороби виражені менш помітно, люди рідше звертаються за кваліфікованою допомогою, тому частішають випадки частого рецидиву. Хронічний цистит загострюється на тлі приховано протікає захворювання внутрішніх органів, тому важливо вчасно діагностувати хворобу і почати адекватну терапію.
Рецепти народної медицини
Напад циститу в домашніх умовах можна зупинити за допомогою народної медицини. Якщо її застосовувати разом з традиційним лікуванням, то саме позбавлення від захворювання може проходити швидше. Проте перед тим як почати використовувати рецепти народної медицини, необхідно проконсультуватися з лікарем.
Саме він розробить схему і встановить тривалість курсу лікування. Пам’ятайте, займатися самолікуванням не можна, тому що це викличе тільки ускладнення. Лікувати хронічний цистит будинку можна таким чином:
- Збалансуйте харчування.
- Додавайте у страви менше солі, приправ і спецій.
- Відмовтеся від міцного чаю і кави.
- Вживайте достатню кількість рідини в день. Найкраще підійде мінеральна вода, відвари і настої лікарських трав. Відвари або настої можна приготувати за такими рецептами:
- Настій плодів шипшини. Вам знадобиться сорок грамів плодів і півтора літра води. Покладіть шипшина в емальований посуд, залийте водою і варіть після кипіння протягом п’ятнадцяти хвилин. Потім вимкніть газ і укутайте в тепле, нехай настоїться протягом сорока хвилин. Після цього, його можна пити, як чай, додаючи для солодощі трохи меду.
- Настій з деревію, ромашки. Візьміть по двадцять грамів сухих рослин і засипте їх у термос. Залийте до верху окропом і закрийте на дві години. Приймати три рази, можна додавати мед.
- Домашній морс з журавлини. П’ятсот грамів ягід, перетирають з цукром, в кількості трьохсот грамів. Потім отриману масу перекладають у скляну банку. Морс можна додати в чай або ж споживати як варення.
Симптоми при загостренні
Часта поява запалення сечового міхура свідчить про наявність хронічної форми циститу. Це пов’язано з тривалими за часом запальними процесами, в результаті яких стінки сечового міхура змінюються.
Під сечею розуміється пройшла обробку рідина, яка виводиться з нирок через сечовивідну систему. Тому внаслідок того, що сечовий міхур переповнений, проводиться виділення сечі, що провокує сфінктер.
При циститі спорожнення сечового міхура відбувається з неприємними відчуттями, які пов’язані із запаленням сечового міхура або сечівника.
Запалення сечового міхура проявляється наступним чином:
- З’являється сильний біль внизу живота. Особливо це проявляється, якщо сечовий міхур переповнений або при його спорожнення.
- Ріжучий больовий синдром під час виділення сечі.
- Постійне бажання відвідати вбиральню. Особливо цей факт проявляється в нічний час доби. Є відчуття, що сечовий міхур спорожнений не до кінця.
- Сеча стає каламутною і виділяється малими порціями. Можна помітити присутність в сечі крові, особливо в кінці сечовипускання.
- Неможливість утримати сечу в сечовому міхурі. Проявляється цей симптом дуже різко, що негативно позначається на психоемоційному стані хворого.
Особливо лякають ознаки циститу маленьких дітей. Дитина відчуває себе некомфортно і відчуває сильне потрясіння. Якщо дитина занадто часто плаче, то варто негайно показати його лікаря.
Звернутися до лікаря потрібно при симптомах запалення сечового міхура відразу, так як діти з працею їх переносять. Якщо цистит виникає у дитини постійно, то необхідно зайнятися підвищенням імунних сил і дотримуватися заходів профілактики.
У деяких випадках, занадто часте поява циститу є причиною виникнення інших не менш «нешкідливих» захворювань нирок, тому так важливо відвідувати лікаря і стежити за своїм здоров’ям. Якщо цистит має хронічну форму, то потрібно якомога частіше відвідувати лікувальні заклади, щоб він не перейшов у більш складну форму.
При черговому нападі хронічного циститу у пацієнта спостерігаються симптоми, схожі з гострою стадією перебігу недуги. При цьому ознаки прояви запалення сечового міхура можуть зберігатися близько семи днів, а потім змінитися періодом ремісії.
Загострення цього захворювання супроводжується наступною специфічною симптоматикою:
- Крім частих позивів до сечовипускання, урина набуває мутний відтінок, різкий неприємний запах.
- В сечі можлива наявність кров’яних виділень, які свідчать про розвиток гематурії. Гемороїдальний цистит розвивається на тлі порушення кровоциркуляции в стінках полого органу видільної системи.
- При вкрай тяжкому перебігу захворювання лікарі діагностують імперативний характер сечовипускання, полягає в тому, що порушуються скорочувальні здібності сечового міхура. В результаті такого прояву загостреного циститу у хворого діагностується енурез (нетримання урини).
- Болі спазматичного характеру у області попереку, які можуть свідчити про початковому етапі розвитку пієлонефриту. Така форма ускладнення запалення полого органу видільної системи виникає у пацієнтів у ситуаціях, коли інфекція вражає ниркові балії.
- На тлі ниркових патологій ускладнення циститу хронічної форми провокують процеси інтоксикації. При цьому пацієнти скаржаться на блювотні позиви, лихоманку, запаморочення.
Найбільш часті і характерні симптоми хронічного циститу наступні:
- часте бажання сходити в туалет, при цьому кількість сечі невелике;
- хворобливі відчуття при сечовипусканні;
- потемніння забарвлення сечі;
- різкі болі в поперековому відділі;
- підвищення температури тіла до 38-39 градусів;
- на тлі інтоксикації з’являється нудота, блювота, запаморочення, слабкість.
Способи терапії
Якщо хронічний цистит загострився, терміново слід почати приймати лікарські препарати. Але варто пам’ятати, що призначення ліків, може проводити тільки лікар. Якщо ви вирішили займатися самолікуванням, все одно краще уточнити у лікаря, які саме лікарські препарати необхідно приймати.
У цьому питанні допоможе уролог. Всі призначення ліків будуть проведені на основі одержаних результатів аналізів і обстежень. Якщо швидко була підібрана ефективна терапія, яку почали вчасно, тоді можна буде з легкістю впоратися з цією недугою за короткий час.
Спосіб терапії та препарати має призначати тільки досвідчений лікар-уролог, якщо ви не змогли потрапити до нього на прийом, тоді допоможе терапевт. Він підбере відповідне лікування, яке буде комплексним. В основному це буде усунення інфекції і відновлення організму.
А що ж робити, якщо ознаки захворювання не минають протягом декількох днів після початку лікування? У цьому випадку необхідно зробити повторне обстеження і призначити аналізи. Може бути, лікарі виявлять бактеріальний цистит. Тоді лікар призначить застосування інших ліків.
Якщо таких ліків вдома немає, тоді до відвідин лікаря слід скористатися гарячою грілкою і випити велику кількість рідини.
Дитячий цистит лікується такими ж препаратами, що і у дорослих. Їм також прописують вживання великої кількості рідини. Якщо у дитини немає алергії, тоді призначається фітотерапія. Це може бути відвар брусниці або ромашки.